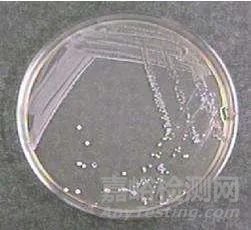
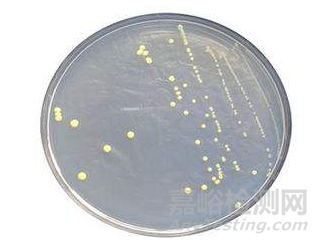
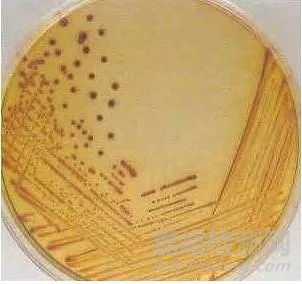

您當前的位置:檢測資訊 > 實驗管理
嘉峪檢測網(wǎng) 2024-10-17 18:31
1、平板劃線
平板劃線的操作是為了將菌稀釋從而獲得純培養(yǎng)的單菌落。劃線有多種方式。
1.1三區(qū)平板劃線
三區(qū)劃線中第一區(qū)所占的區(qū)域大約是平板面積的五分之一到四分之一。第二區(qū)搭過第一區(qū)的面積使微生物數(shù)量得到“稀釋”,第三區(qū)搭過第二區(qū)的面積使微生物數(shù)量進一步“稀釋”,第三區(qū)不可與第一區(qū)有重疊的劃線。一般適用于可疑菌落的分離,或可疑菌落的二次平板分離。通常劃完三區(qū)后就可以出現(xiàn)單菌落。三區(qū)劃線如下圖。

1.2四區(qū)平板劃線
四區(qū)平板劃線與上面的三區(qū)劃線類似,只是每一區(qū)的劃線面積相應減小,同樣第三區(qū)不可與第一區(qū)相重疊,第四區(qū)不可與第二區(qū)和第一區(qū)相重疊,四區(qū)劃線比三區(qū)劃線多稀釋一次,這樣通過增加劃線區(qū)域,有可能會分離到更多更純的單菌落。
1.3單次連續(xù)“之”字平板劃線
其實在微生物劃線接種中,無論是試管斜面劃線接種還是平板劃線接種,都會用到“之”字劃線。“之”字劃線的要領(lǐng)是:往復不間斷劃線,但是又不與劃過的路線重復或重疊。如果菌量比較大,就可以劃得更為密集或者增加一塊平板繼續(xù)“之”字劃線(即連續(xù)劃兩塊板)。“之”字劃線一般適用于分離本身在此培養(yǎng)基上單一且黏性較大的菌類或可疑菌落的純培養(yǎng)。操作如下圖所示。
1.4網(wǎng)狀平板劃線
網(wǎng)狀平板花線,其實就是兩次方向垂直的“之”字劃線重疊在一起,一般用于純培養(yǎng),目的是通過增加更多的劃線路徑來獲得更多的純培養(yǎng)物,特別是針對一些生長較慢或菌落非常細小的菌類。
在以上的這些平板劃線的方式中,三區(qū)平板劃線最常用的是分區(qū)劃線法,詳細操作步驟見下圖。

① 將接種環(huán)放在火焰上灼燒,直到接種還環(huán)燒紅。
② 在火焰旁冷卻接種換環(huán),打開試管塞。
③ 將試管口通過火焰,旋轉(zhuǎn)試管口并小幅度來回移動試管,切不可長時間讓試管口停滯于火焰上加熱。
④ 將已冷卻的接種環(huán)伸入菌液中,挑取一環(huán)菌液。
⑤ 將試管口通過火焰幾次后,塞上試管塞。將試管放回試管架。
⑥ 左手拿起培養(yǎng)皿,將培養(yǎng)皿蓋打開一條縫隙,右手將沾有菌液的接種環(huán)迅速深入平皿內(nèi)。從平皿邊緣開始“之”字劃線(基準線也稱第一區(qū)域),大約劃過平皿的五分之一到四分之一左右的面積。關(guān)閉培養(yǎng)皿蓋,將培養(yǎng)皿調(diào)轉(zhuǎn)大約120°。再次灼燒接種環(huán),將接種環(huán)在空氣中或靠在培養(yǎng)皿蓋內(nèi)側(cè)冷卻后從第一區(qū)域末端開始往第二區(qū)內(nèi)劃線。兩個區(qū)域劃線的交角大約是120°。重復以上動作,完成第三區(qū)(甚至第四區(qū))劃線操作。注意:當前操作的劃線只能與相鄰前一區(qū)域相交,絕不能與其他區(qū)域的劃線有重疊。
一般三區(qū)劃線就能分離出單菌落,理想的三區(qū)分區(qū)劃線平板培養(yǎng)后的結(jié)果見下圖。第一區(qū)和第二區(qū)前部的細菌生長成“直線”,第二區(qū)后部的細菌生長呈“虛線”。第三區(qū)呈“虛線”和離散的“小點”(即單菌落)。
2、平板傾注
平板傾注接種的步驟具體操作如圖。

1.先在酒精燈火焰旁打開無菌空平皿,注意開啟幅度不宜過大,加入一定量的樣液。
2.按“倒平板”的步驟加入培養(yǎng)基(注意培養(yǎng)基要水浴保溫在46°左右,溫度太低,培養(yǎng)基容易凝固,溫度太高容易燙傷細菌)。
3.將平皿蓋上蓋。在桌面劃圓圈滑動,幅度不要太大以免培養(yǎng)基灑漏或濺到平皿皿蓋?;旌暇鶆蚝?,將平皿置于桌面,待平皿凝固后,翻轉(zhuǎn)平皿堆疊放于培養(yǎng)箱中培養(yǎng)。有時還會在凝固的培養(yǎng)基表面再倒一層培養(yǎng)基,防止蔓延菌落的出現(xiàn)。
3、平板涂布
平板涂布是將少量(通常0.2mL~0.5mL)系列稀釋的菌液涂布在預先傾注好的固體培養(yǎng)基上,靠涂布棒在瓊脂表面均勻鋪開,培養(yǎng)后獲得菌落個數(shù)的一種計數(shù)技術(shù)。平板涂布的操作如圖。

1.無菌移取一定量樣液于平皿固體培養(yǎng)基中央。
2.玻璃涂布棒蘸取酒精。注意始終保持涂布棒的涂布一端向下,并且涂布棒上的酒精既要覆蓋全部即將深入平皿的部位又不能滴淌。
3.通過酒精燈火焰點燃。一定注意防止酒精倒流或濺溢引燃物品或燒到手。
4.左手將皿蓋在酒精燈火焰旁邊打開一個縫隙,右手將灼燒過的涂布棒涂布一端靠在皿蓋上冷卻。冷卻后將平皿蓋開大一些,用涂布棒刮樣液在培養(yǎng)基表面均勻涂布開。涂布的時候,涂布棒不能觸碰平皿內(nèi)側(cè)邊緣。如果有條件,涂布過程應將平皿置于旋轉(zhuǎn)的涂布臺上。
5.涂布棒再次蘸取酒精,通過火焰點燃滅菌。
6.待平皿表面液體晾干后,翻轉(zhuǎn)平皿,置于培養(yǎng)箱培養(yǎng)。

來源:Internet